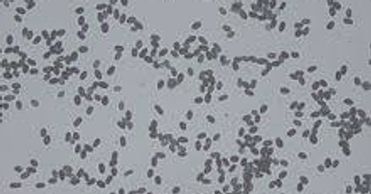

- Home
- Air Quality Testing
- Mold Inspection
- Contact Us
- Verify Air Quality Blog
- Office Air Test
- Indoor Air Quality
- Smoke Damage Testing
- Mold Library
- Facts
- Us in News
- Air Quality Test Markham
- Air Test in Mississauga
- Indoor Air Mississauga
- Mould Testing Mississauga
- Mould Testing Markham
- FAQ Home Air Quality Test
- FAQ Mould Remediation
- FAQ Office Air Test
- Indoor Air Test Markham
- Office and Home Air Test
- Toronto Air Quality Test
- Daily Air Quality Advice
- Book Checklists
- Air Quality Book
- Mold And Mycotoxin Book